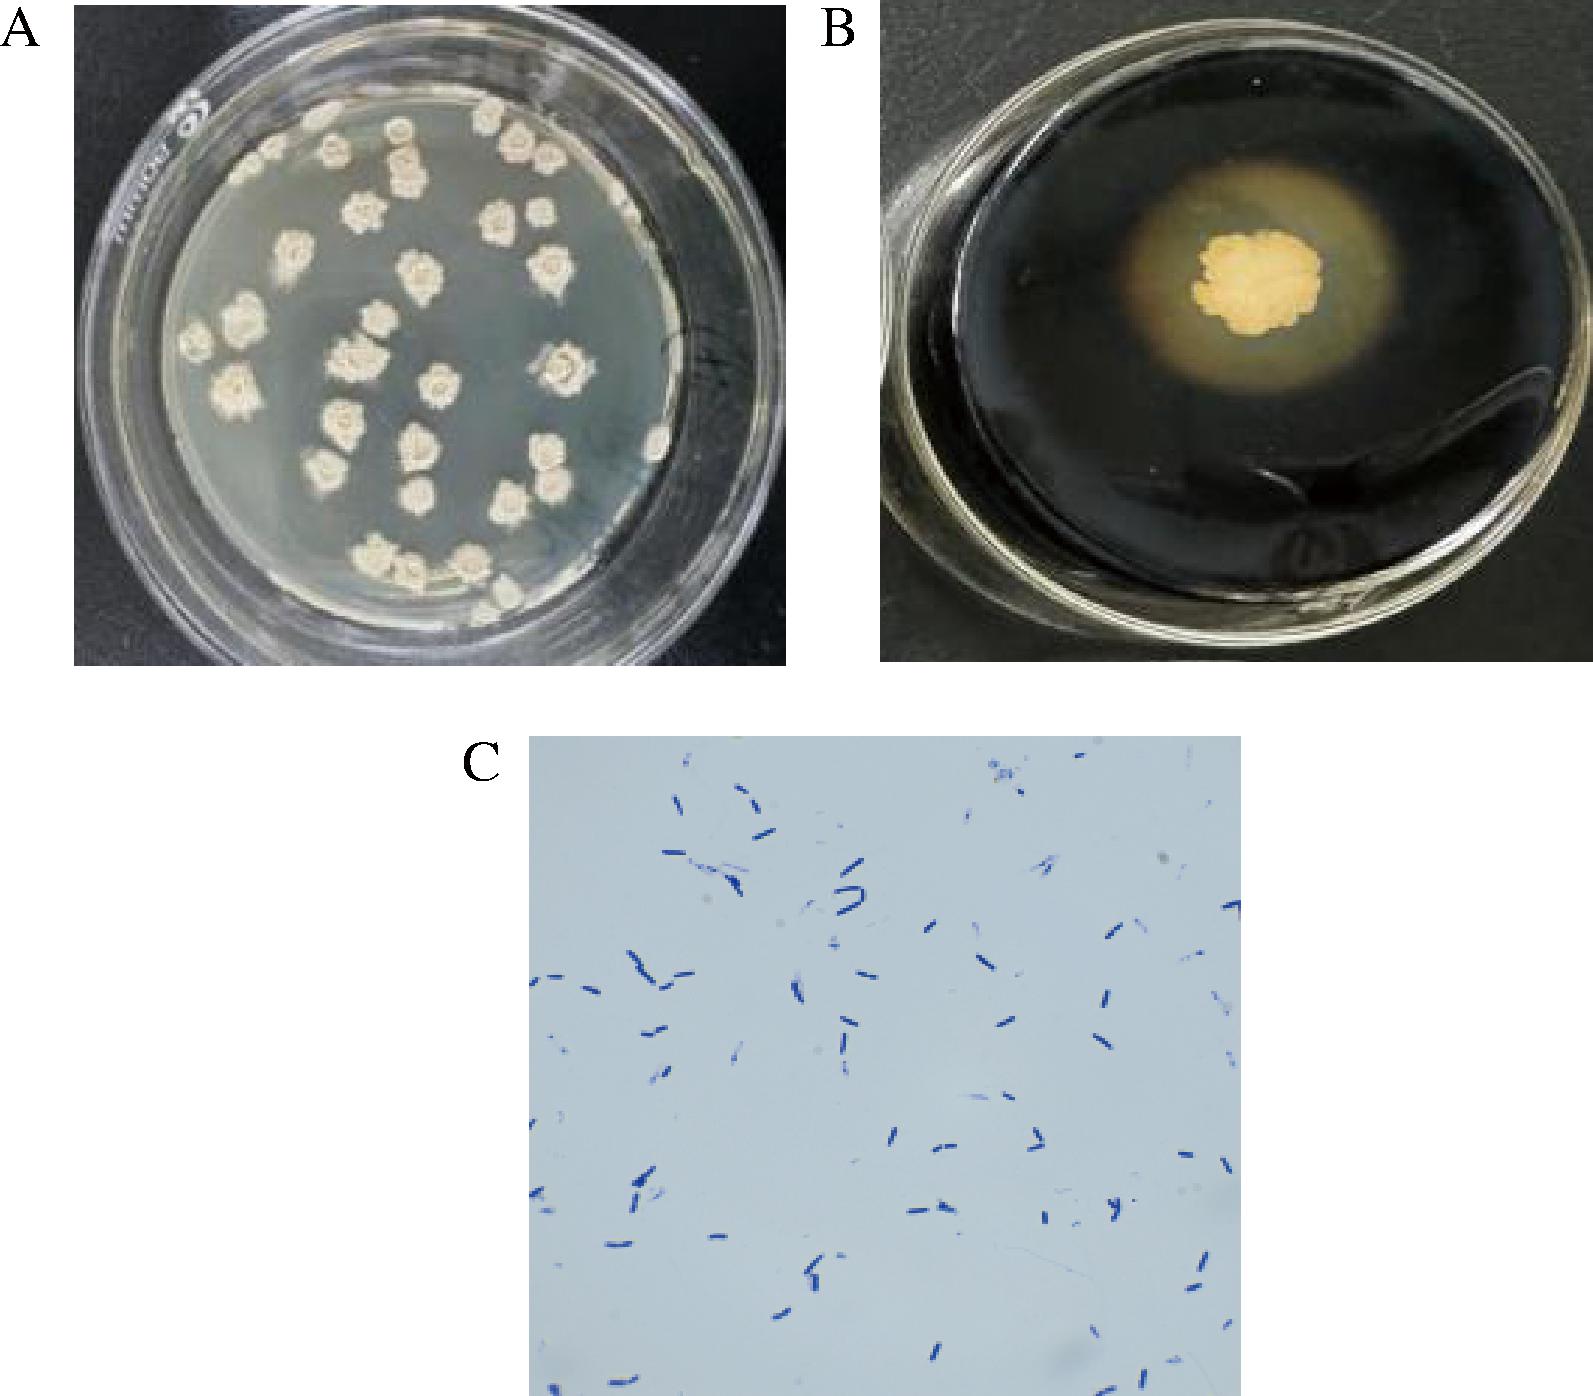

青稞酒源于我国青藏高原地区,是中国传统的蒸馏酒之一,其酿造过程依赖酒曲作为发酵动力源。酒曲是白酒酿造中的传统发酵剂,由多种微生物共同发酵谷物中的碳水化合物后形成,含有丰富的功能微生物群落和代谢酶,既能保障发酵进程的顺利进行,又可促进白酒特有风味化合物的形成[1]。酶是酒曲的重要组成部分,包括淀粉酶类、酯化酶类、蛋白酶类、脂肪酶类和单宁酶类等[2],其中淀粉酶通过水解淀粉生成可发酵糖类,为酒精发酵奠定物质基础,对提升发酵速率和出酒率具有关键作用[3]。淀粉酶等酶制剂在食品加工、酿造等领域应用广泛[4-5]。产淀粉酶的菌株包括放线菌、芽孢杆菌、霉菌和酵母菌等[6],其中芽孢杆菌属在酒曲微生物中占据主导地位,具有产酶量高、发酵周期短及耐酸碱、耐高温等特性[7-8]。该菌属中贝莱斯芽孢杆菌、枯草芽孢杆菌、地衣芽孢杆菌等菌种已确认具有胞外淀粉酶分泌特性[9]。近年来胡晓龙等[10]和毛祥等[11]已从大曲、糟醅、窖泥等中筛选出了许多株高产淀粉酶的芽孢杆菌。生产实践显示酒醅中添加此类功能菌株能够提高基酒出酒率[12],在酿酒工业中具有突出的生物强化潜力。因此,筛选高产淀粉酶微生物菌株对于提高发酵酒的生产效率和降低发酵成本具有现实意义。
1 材料与方法
1.1 材料与试剂
青稞酒曲由青海天佑德青稞酒股份有限公司提供。
实验试剂:蛋白胨、牛肉浸粉、琼脂粉等,上海长青化工有限公司;3,5-二硝基水杨酸,安徽中弘生物工程有限公司;淀粉含量检测试剂盒,南京建成生物工程研究所。
1.2 培养基
固体培养基(g/L):蛋白胨10.0,NaCl 10.0,牛肉浸粉5.0,琼脂粉15.0。
筛选培养基(g/L):蛋白胨10.0,NaCl 5.0,牛肉浸粉5.0,可溶性淀粉10.0,琼脂粉15.0。
发酵培养基(g/L):蛋白胨10.0,NaCl 10.0,可溶性淀粉10.0。
液体培养基(g/L):蛋白胨10.0,牛肉浸粉5.0,NaCl 10。
以上培养基均于121 ℃下高压蒸汽灭菌20 min。
1.3 仪器与设备
尼康YS100生物显微镜,上海蔡康光学仪器有限公司;SPX-450FT恒温生化培养箱,宁波市普朗特仪器有限公司;HNY-100B恒温培养振荡器,天津市欧诺仪器仪表有限公司;立式蒸汽灭菌锅DGL-75B,江苏登冠医疗器械有限公司;Varioskan LUX多功能酶标仪,Thermo Fisher公司。
1.4 实验方法和研究内容
1.4.1 产淀粉酶菌株的分离纯化
参照刘宁等[13]的方法并适当调整。称取5 g青稞酒曲与45 mL无菌水在三角瓶中充分混匀(200 r/min,2 h),梯度稀释后涂布200 μL于筛选培养基平板上,以37 ℃培养24 h,挑选出具有透明圈的单菌落并经3代及以上传代培养。单菌落转接液体培养基后,在37 ℃、150 r/min条件下培养24 h。菌液使用50%甘油按1∶4(甘油∶菌液)体积比混合后在-80 ℃的冰箱保存,用于后续实验。
1.4.2 产淀粉酶菌株的筛选
初筛:将纯化的菌株单菌落点种于筛选培养基平板中,37 ℃、24 h培养后加入碘液铺满整个培养基,静置数分钟后测量透明圈直径(D)与菌落直径(d)之比(D/d),选择D/d值>1.5的菌株进行复筛。
复筛:将初筛菌株在37 ℃、150 r/min条件下液体培养24 h。调整菌液OD600值0.5±0.05,并以6%的接种量接种于发酵培养基中同参数发酵48 h。取发酵液离心(8 000 r/min,10 min)后的上清液即为粗酶液。根据王祯瑜[14]方法,采用3,5-二硝基水杨酸法测定淀粉酶活力,筛选高产淀粉酶菌株。
淀粉酶活力单位定义:在pH 6.0缓冲体系条件中,60 ℃水解质量浓度为2%的可溶性淀粉30 min,计算生成1 mg葡萄糖所需的酶量,定义为一个酶活力单位(U)。
1.4.3 菌株KC-4的菌种鉴定
形态学和生理生化鉴定:革兰氏染色后依据《伯杰细菌鉴定手册》(第8版)对菌落的形态特征进行观察。挑取菌株KC-4的单菌落,接种于相应的培养基中,根据杨心意[15]的方法检测纤维素、淀粉、酪素等的水解情况。
分子生物学鉴定:菌株经斜面培养后送检。DNA提取及ITS测序由生工生物工程(上海)股份有限公司完成。测序数据经NCBI GenBank数据库BLAST比对筛选高同源序列,并采用MEGA11.0邻接法(NJ)构建系统发育树。
1.4.4 菌株KC-4生长曲线、酶活曲线及淀粉降解率曲线测定
将菌株接种至发酵培养基中以37 ℃摇床(150 r/min)培养。每2 h连续取样,测定发酵液的OD600值,绘制生长曲线。每3 h连续取样,测定发酵液淀粉酶活力,绘制淀粉酶酶活力曲线[10]。每12 h连续取样,用淀粉含量试剂盒测定发酵液中的淀粉含量,根据公式(1)计算得到淀粉降解率,绘制淀粉降解率曲线:
淀粉降解率![]()
(1)
式中:A0为初始青稞水提物淀粉含量;A1为不同时间段发酵液淀粉含量。
1.4.5 菌株KC-4的生物学特性分析
探究不同培养温度、初始pH、NaCl质量分数、葡萄糖质量分数、酒精体积分数对菌株生长的影响。采用液体培养,设定培养温度(7、25、30、35、37、40、45、50、60 ℃),初始pH 7.0;设定初始pH值(4.0、5.0、6.0、7.0、8.0、9.0、10.0),培养温度37 ℃;设定NaCl质量分数(0%、1%、3%、5%、7%、9%、10%、15%),初始pH 7.0,培养温度37 ℃;设定葡萄糖质量分数(0%、2%、10%、15%、20%、25%、30%、35%、40%),初始pH 7.0,培养温度37 ℃;设定酒精体积分数(0%、3%、6%、8%、10%、12%、14%、16%、18%、20%),初始pH 7.0,培养温度37 ℃。在150 r/min的条件下培养24 h后,测定各组的OD600值[16]。
1.4.6 菌株KC-4的酶学特性
酶学特性研究参考杜东晓等[17]和韩鲁鲁[18]的方法并稍作修改。
最适反应温度和热稳定性:在pH 6.0条件下,将粗酶液与2%(质量分数)淀粉溶液混匀,分别在30、40、50、60、70、80、90 ℃下进行反应,测定各温度点的酶活力,并以酶活力最高的温度对应的酶活力作为基准(100%)计算其他温度点的相对酶活力,确定最适反应温度。将粗酶液分别置于30、40、50、60、70、80、90 ℃的水浴保温10、20、30、40、50、60 min,孵育结束后,将酶液与含有2%(质量分数)可溶性淀粉的缓冲液于最适温度下进行反应,测定不同温度、不同保温时间下的酶活力,以初始酶活力为基准(100%)计算相对酶活力,从而分析该酶在不同温度和保温时间下的热稳定性。
最适反应pH和酸碱稳定性:在最适反应温度60 ℃条件下,分别测定粗酶液在pH 3.0、4.0、5.0、6.0、7.0、8.0、9.0时的酶活力,并以酶活力最高的pH值对应的酶活力作为基准(100%)计算其他组的相对酶活力,确定最适反应pH。将粗酶液分别置于pH 3.0、4.0、5.0、6.0、7.0、8.0、9.0的缓冲液中,在60 ℃水浴保温10、20、30、40、50、60 min,孵育结束后,将酶液与含有2%可溶性淀粉的缓冲液于最适温度下进行反应,测定在不同pH、不同保温时间下的酶活力,以初始酶活力为基准(100%)计算相对酶活力,从而分析该酶在不同pH和保温时间下的酸碱稳定性。
最适反应金属离子和金属离子稳定性:将粗酶液与0.1 mol/L的Na+、Ca2+、Mn2+、Fe2+、Ba2+、Mg2+、K+金属离子盐溶液等体积混合,最终使金属离子盐浓度为0.05 mol/L,在最适反应温度和pH下,测定不同金属离子条件下的淀粉酶活力,并以酶活力最高的金属离子对应的酶活力作为基准(100%)计算其他组的相对酶活力。将粗酶液分别在最适反应温度60 ℃和最适反应pH 7.0下水浴保温10、20、30、40、50、60 min,以未加金属离子的反应体系作为对照,测定不同保温时间下的酶活力,以初始酶活力为基准(100%)计算相对酶活力,从而分析该酶在不同金属离子和保温时间下的金属离子稳定性。
1.5 数据处理
采用SPSS 27.0进行统计学分析,采用Origin 2025作图,显著性分析采用字母标记法。所有实验重复3次,数据均以“平均值±标准差”形式表示。
2 结果与分析
2.1 产淀粉酶菌株的筛选结果
从青稞酒曲中分离纯化出5株产淀粉酶菌株,产淀粉酶能力如表1所示。
表1 产淀粉酶菌株的筛选结果
Table 1 Screening results of amylase-producing strains

菌株编号D/d值淀粉酶活力/(U/mL)KC-12.03±0.3222.05±0.50KC-41.91±0.3329.29±0.60KC-51.77±0.1428.35±0.59KC-61.56±0.427.92±0.48KC-A12.04±0.5223.90±0.16
由表1可见,其透明圈D/d值大小依次是KC-A1>KC-1>KC-4>KC-5>KC-6,淀粉酶活力高低依次是KC-4>KC-5>KC-A1>KC-1>KC-6,其中淀粉酶活力最高的为KC-4,因此挑取这一株菌株进行后续实验。
2.2 产淀粉酶菌株的鉴定
2.2.1 形态学和生理生化特征鉴定
菌株KC-4在平板上的菌落形态、透明圈及革兰氏染色见图1。
A-菌落形态;B-菌株透明圈;C-革兰氏染色后镜检
图1 菌株KC-4菌落形态、透明圈及革兰氏染色
Fig.1 Colony morphology, transparent circle, and Gram staining of strain KC-4
由图1-A可知,菌株KC-4呈白色,后发黄,形态圆形或略不规则,表面微皱或内凹,边缘轻微波浪状。图1-B可清晰看到菌株KC-4淀粉水解圈,可知菌株具有降解淀粉的能力。图1-C是用光学显微镜观察菌株KC-4革兰氏染色后的结果,可知KC-4为革兰氏阳性菌,细胞形态为直杆状,芽孢位于细胞中部或接近中部。
生理生化实验结果见表2。
表2 菌株KC-4部分生化特性鉴定结果
Table 2 Identification results of partial biochemical characteristics of strain KC-4

实验内容实验结果实验内容实验结果实验内容实验结果纤维素分解+氧化酶+过氧化氢酶+淀粉水解+硝酸盐还原-甲基红-酪素水解+最适生长温度37 ℃最适初始pH7.0最适NaCl质量分数2%最适葡萄糖质量分数2%最适酒精体积分数3%
由表2可见,该菌的纤维素分解实验(+)、淀粉水解实验(+)、过氧化氢酶实验(+)、氧化酶实验(+)、硝酸盐还原实验(-)、甲基红实验(-)和酪素水解实验(+),最适生长温度37 ℃、最适初始pH 7.0、最适NaCl质量分数2%、最适葡萄糖质量分数2%、最适酒精体积分数3%,符合枯草芽孢杆菌的生理生化特征。
2.2.2 分子生物学鉴定
基于16S rDNA基因序列构建菌株KC-4的系统发育树,结果见图2。

图2 基于16S rDNA基因序列构建菌株KC-4的系统发育进化树
Fig.2 Phylogenetic tree of strain KC-4 based on the 16S rDNA gene sequence
由图2可知,菌株KC-4与枯草芽孢杆菌亲缘关系最为接近,结合菌落形态观察和生理生化实验的鉴定结果,可以确定菌株KC-4为枯草芽孢杆菌(Bacillus subtilis)。
2.3 菌株KC-4的生长曲线、酶活力曲线及淀粉降解率曲线
菌株KC-4的生长曲线、酶活力曲线及淀粉降解率曲线结果如图3所示。

A-生长曲线、酶活力曲线;B-淀粉降解率曲线
图3 菌株KC-4的生长、酶活曲线及淀粉降解率曲线
Fig.3 Curve of growth, enzyme activity, and starch degradation rate of strain KC-4
注:不同小写字母表示差异显著(P<0.05),凡有一个相同字母的即为差异不显著(P>0.05)(下同)。
由图3-A可知,该菌株在24 h前生长速度较快,处于对数生长期,而24 h后菌体浓度逐渐趋于稳定,进入生长稳定期,并在33 h达到最大生物量。酶活力曲线显示18 h前酶活力受限(<5 U/mL),在21 h后进入稳定产酶期,在48 h达产酶峰值(28 U/mL)。由图3-A显示,菌体生长与产酶过程存在一定的偶联关系,但并不完全同步。菌株KC-4的淀粉降解率曲线如图3-B,该菌株在前24 h降解淀粉的能力持续提升,在48 h淀粉降解率达到最大,并趋于稳定。菌株KC-4的生长峰值(33 h)早于产酶高峰(48 h),提示其淀粉酶合成可能受营养耗尽或代谢产物积累诱导,属于典型的次级代谢产物合成模式,此特性需在工业应用中通过延长发酵周期或优化营养供应以最大化酶产量[19-20]。
2.4 菌株KC-4的生物学特性分析
2.4.1 温度对菌株KC-4生长的影响
温度对菌株KC-4生长的影响如图4所示。

图4 温度对菌株KC-4生长的影响
Fig.4 Effect of temperature on growth of strain KC-4
发酵温度升高能够加速酶促反应,但过高的温度可能会破坏细胞膜的结构,导致酶失活,进而抑制细胞的代谢活动[21]。由图4可知,在相同发酵时间下,该菌在37 ℃时培养的发酵液OD600值最大,适宜生长的温度高于一般发酵型菌株的生长温度。当温度达到40 ℃时,菌株生长虽受到一定程度的抑制,但在40~60 ℃内OD600值仍在0.4以上,显示出良好的耐温性。在酒类酿造过程中,由于糖化和发酵过程中升温幅度较大,耐温性较强的微生物能更好地适应这一过程[22]。基于此,菌株KC-4在发酵酒的生产中具有广阔的应用前景。
2.4.2 初始pH对菌株KC-4生长的影响
初始pH对菌株KC-4生长的影响如图5所示。

图5 初始pH对菌株KC-4生长的影响
Fig.5 Effect of initial pH on growth of strain KC-4
pH值能影响微生物细胞内的电解质平衡,进而影响其生长代谢[23]。由图5可知,该菌在pH 5.0~9.0内,菌株表现出良好的生长状态,且在pH值为7.0条件下的生长情况明显优于其他pH条件,然而pH值为4.0、10.0条件下,菌株几乎不能生长。因此,该菌株在弱酸性条件下仍能保持一定的活性,与酒曲发酵初期酸性环境相适应[24];而在弱碱性条件下,尽管生长速度有所减缓,但芽孢形成能力增强,这有助于其在发酵后期或贮存期的存活,进一步凸显了该菌株在传统发酵体系中的生态适应性优势[25]。
2.4.3 NaCl对菌株KC-4生长的影响
NaCl对菌株KC-4生长的影响如图6所示。

图6 NaCl质量分数对菌株KC-4生长的影响
Fig.6 Effect of NaCl concentration on growth of strain KC-4
由图6可知,培养基的NaCl质量分数为0%~9%时菌株生长状况良好,最适NaCl质量分数为1%,当NaCl质量分数超过9%时,菌株的生长会受到明显的抑制。该菌具有一定的耐盐能力,推测可能通过积累相容性溶质(如脯氨酸、甜菜碱)或调节细胞膜组成来应对高渗透压胁迫(如酒曲中的高糖或高盐条件),从而维持细胞稳态并确保生长活力[26]。
2.4.4 葡萄糖对菌株KC-4生长的影响
葡萄糖对菌株KC-4生长的影响如图7所示。

图7 葡萄糖质量分数对菌株KC-4生长的影响
Fig.7 Effect of glucose mass fraction on growth of strain KC-4
葡萄糖是发酵生产乙醇的关键底物,也是菌株生长的能源物质。其浓度梯度显著影响枯草芽孢杆菌增殖,高浓度糖会抑制菌株生长,高渗透压会导致枯草芽孢杆菌细胞失水。如图7所示,当葡萄糖质量分数为2%时,菌体浓度最大,生长最好。该菌株在较高糖浓度(如10%~20%葡萄糖质量分数)下仍能维持生长,但增殖速率随糖浓度升高而降低,表现出典型的渗透压应激响应。低糖条件(<2%)下菌株快速进入对数期,而高糖环境(>10%)则延长延迟期,提示细胞需要时间合成相容性溶质以平衡胞内外渗透压[26]。
2.4.5 酒精对菌株KC-4生长的影响
酒精对菌株KC-4生长的影响如图8所示。

图8 酒精体积分数对菌株KC-4生长的影响
Fig.8 Effect of ethanol volume fraction on growth of strain KC-4
酒精是大曲中酵母菌厌氧发酵的产物。高浓度酒精环境引发微生物代谢胁迫,酒精对细胞的抑制作用较为复杂,主要体现在抑制微生物的增殖速度、存活能力以及发酵效率3个方面[27]。由图8可知,菌株KC-4的生长在酒精体积分数3%时菌体浓度最大,之后酒精含量增加,其菌体浓度逐渐下降。但菌株KC-4在酒精体积分数在10%以内均能维持基础代谢(OD600>0.4);当浓度阈值突破12%时则完全生长抑制(OD600≈0.1)。
2.5 菌株KC-4的酶学特性
2.5.1 淀粉酶的最适反应温度及热稳定性
菌株KC-4淀粉酶最适反应温度及热稳定性如图9所示。

A-温度对淀粉酶活力的影响;B-淀粉酶的热稳定性
图9 淀粉酶的最适反应温度及热稳定性
Fig.9 Optimal reaction temperature and thermal stability of the amylase
由图9-A可知,该菌株产生的淀粉酶的最适反应温度为60 ℃,此时具有最高酶活力,说明该淀粉酶为耐热淀粉酶。在30~90 ℃内呈现先上升后下降的趋势,但都保持60%以上的相对酶活力,可见该淀粉酶的适用温度范围较广,显示出良好的应用潜力。
由图9-B可知,淀粉酶活力随着保温时间的延长都缓慢下降,在30~80 ℃下保温1 h均可保持50%以上的相对酶活力,说明该淀粉酶在较高温度下能保持相对稳定;且在60 ℃下保温1 h后可保持75%以上的相对酶活力,热稳定性最好,在90 ℃时的热稳定性最差,但仍能达到30%的相对酶活力。因此,该菌株的淀粉酶耐热性良好,可直接用于酒曲强化或开发耐热淀粉酶制剂,具有较好的商业化潜力。此外,淀粉酶在60 ℃下的高热稳定性与白酒蒸馏前的高温糖化工艺高度契合,减少了酶失活风险[28]。
2.5.2 淀粉酶的最适反应pH及酸碱稳定性
菌株KC-4淀粉酶最适反应pH及酸碱稳定性如图10所示。

A-pH对淀粉酶活力的影响;B-淀粉酶的酸碱稳定性
图10 淀粉酶的最适反应pH及酸碱稳定性
Fig.10 Optimal reaction pH and acid-alkali stability of the amylase
由图10-A可知,该菌所产淀粉酶的最适反应pH值为7.0,在 pH 3.0~9.0时呈现先上升后下降的趋势,但都保持40%以上的相对酶活力。在pH 5.0~9.0时,酶活力均能达到最大值的55%以上,说明该淀粉酶在较宽的pH范围内具有较高的活力,其中在pH 5.0~6.0是青稞酒发酵初期的酸性环境,表明其适应性强,与发酵工艺中自然pH波动高度匹配甚至更为广泛[29],具有较好的应用前景;且淀粉酶的最适pH值与菌株最适生长pH值一致(均为7.0),说明其代谢系统与酶功能协同进化,适应发酵过程中pH的自然波动。
由图10-B可知,菌株KC-4的淀粉酶在pH 6.0~8.0保温60 min后相对酶活力仍在55%以上,表现出较好的稳定性,且在pH 7.0时,酸碱稳定性最好。在pH 3.0时,随着保温时间的延长,淀粉酶活力下降最快,但仍能保持40%以上的相对酶活力。在pH 7.0、8.0和 9.0时,酶活力下降相对缓慢,说明该淀粉酶在碱性条件下较稳定。
2.5.3 金属离子对淀粉酶活力及稳定性的影响
金属离子对菌株KC-4淀粉酶活力及稳定性的影响如图11所示。

A-金属离子对淀粉酶活力的影响;B-金属离子对淀粉酶稳定性的影响
图11 金属离子对淀粉酶活力及稳定性的影响
Fig.11 Effect of metal ions on activity and stability of the amylase
金属离子在酶的活性和稳定性中起着重要作用,不同的金属离子可能会激活、抑制或稳定酶的结构[30]。如图11-A所示,含有Fe2+、Ca2+、Ba2+、Mg2+的发酵液相对酶活力明显高于对照组,表明它们可能是该淀粉酶激活剂,且含有Fe2+、Ca2+的发酵液中相对酶活力明显高于其他组;而Na+和K+相对酶活力低于对照组,表明Na+和K+对该淀粉酶有抑制作用,K+的抑制作用最大,相对酶活力仅有14.48%。
由图11-B可知,培养基中添加K+和Fe2+后,发酵液中的酶活力下降较快,而在添加 Ca2+、Mn2+的培养基中酶活力相对稳定,但由图11-A可知,Ca2+对淀粉酶的激活作用明显大于Mn2+,因此,在工业化生产中可添加Ca2+培养基来强化酶活力,并建立K+浓度预警值,这为工业发酵中金属离子调控提供了直接依据。
3 结论
本研究成功从青稞酒曲中分离出一株淀粉酶高产菌株,鉴定为枯草芽孢杆菌,该菌具有较高的产淀粉酶能力,且具备强环境适应性,可在温度25~60 ℃、pH 5.0~9.0、高盐(≤9% NaCl)、高糖(≤20%葡萄糖)及酒精体积分数≤10%的条件下稳定生长,与青稞酒发酵动态环境高度契合;本研究结果可为该菌用于生产实践提供工艺参数,通过优化发酵环境(如调控温度60 ℃、pH至中性、添加Ca2+)可明显提升淀粉糖化效率,为传统酿造工艺的微生物强化和工业酶制剂开发提供了理论依据与潜在应用菌株。
[1] DU H, WANG X S, ZHANG Y H, et al. Exploring the impacts of raw materials and environments on the microbiota in Chinese Daqu starter[J]. International Journal of Food Microbiology, 2019, 297:32-40.
[2] 李兵, 张超, 王玉霞, 等. 白酒大曲功能微生物与酶系研究进展[J]. 中国酿造, 2019, 38(6):7-12.LI B, ZHANG C, WANG Y X, et al. Research progress on functional microbes and enzymes in Daqu of Baijiu[J]. China Brewing, 2019, 38(6):7-12.
[3] 王禹程. 超声处理解淀粉芽孢杆菌对豆粕固态发酵产肽的影响及其作用机制[D]. 江苏大学, 2021. WANG Y C. Effect of ultrasonic treatment of Bacillus amyloliquefaciens on peptide production from soybean meal by solid-state fermentation and its mechanism[D]. Jiangsu University, 2021.
[4] DE SOUZA P M, DE OLIVEIRA MAGALH ES P. Application of microbial α-amylase in industry-A review[J]. Brazilian Journal of Microbiology, 2010, 41(4):850-861.
ES P. Application of microbial α-amylase in industry-A review[J]. Brazilian Journal of Microbiology, 2010, 41(4):850-861.
[5] RAVEENDRAN S, PARAMESWARAN B, UMMALYMA S B, et al. Applications of microbial enzymes in food industry[J]. Food Technology and Biotechnology, 2018, 56(1):16-30.
[6] 王芙蓉. 酱香型大曲中高温放线菌的筛选及其产酶条件的优化[D]. 贵州大学, 2017.WANG F R. Screening of thermophilic actinomycetes from Maotai flavor Daqu and optimization of enzyme production conditions[D]. Guizhou University, 2017.
[7] 刘晶晶. 大曲酶系和代谢物组分析及其中产复合酶菌株的应用研究[D]. 中国农业大学, 2018.LIU J J. Analysis of enzymes and metabolites in Daqu and application of strains producing compound enzymes[D]. China Agricultural University, 2018.
[8] WANG S H, JEYASEELAN J, LIU Y, et al. Characterization and optimization of amylase production in WangLB, a high amylase-producing strain of Bacillus[J]. Applied Biochemistry and Biotechnology, 2016, 180(1):136-151.
[9] FAROOQ M A, ALI S, HASSAN A, et al. Biosynthesis and industrial applications of α-amylase: A review[J]. Archives of Microbiology, 2021, 203(4):1281-1292.
[10] 胡晓龙, 冯大鸿, 田瑞杰, 等. 中温大曲产淀粉酶菌株的筛选鉴定及培养条件优化[J]. 中国酿造, 2023, 42(1):78-85.HU X L, FENG D H, TIAN R J, et al. Isolation, identification and culture conditions optimization of amylase-producing strains in medium-temperature Daqu[J]. China Brewing, 2023, 42(1):78-85.
[11] 毛祥, 黄丹, 沈才萍, 等. 酱香型大曲中产淀粉酶菌的分离鉴定及发酵特性研究[J]. 中国酿造, 2015, 34(12):24-27.MAO X, HUANG D, SHEN C P, et al. Isolation, identification and fermentation characteristics of amylase-producing strain from Moutai-flavor Daqu[J]. China Brewing, 2015, 34(12):24-27.
[12] 黄晓宁, 刘晶晶, 韩北忠, 等. 基于酶学特性筛选大曲来源芽孢杆菌用于强化酿酒[J]. 食品科学, 2021, 42(10):218-224.HUANG X N, LIU J J, HAN B Z, et al. Screening of Bacillus from daqu by enzymatic characteristics to enhance the fermentation of Chinese Baijiu[J]. Food Science, 2021, 42(10):218-224.
[13] 刘宁, 张宿义, 明红梅, 等. 中温大曲中产淀粉酶芽孢杆菌的筛选鉴定及培养条件优化[J]. 中国酿造, 2023, 42(12):38-44.LIU N, ZHANG S Y, MING H M, et al. Screening, identification and culture conditions optimization of amylase-producing Bacillus strain from medium-temperature Daqu[J]. China Brewing, 2023, 42(12):38-44.
[14] 王祯瑜. 产淀粉酶菌株的筛选与发酵条件的优化及其降解淀粉途径的探讨[D]. 辽宁师范大学, 2022.WANG Z Y. Screening of amylase producing strains, optimization of fermentation conditions and Discussion on starch degradation pathway[D]. Liaoning Normal University, 2022.
[15] 杨心意. 产耐高温α-淀粉酶菌株的筛选、发酵条件优化及酶学性质研究[D]. 塔里木大学, 2013.YANG X Y. Screening of high temperature resistant α-amylase producing strains, optimization of fermentation conditions and enzymatic properties[D]. Tarim University, 2013.
[16] 周阳子, 边名鸿, 刘文艺, 等. 高温大曲中一株产淀粉酶酵母的分离鉴定及其特性研究[J]. 食品与发酵工业, 2020, 46(2):79-84.ZHOU Y Z, BIAN M H, LIU W Y, et al. Isolation and identification of an amylase producing yeast and its characteristics in high-temperature Daqu[J]. Food and Fermentation Industries, 2020, 46(2):79-84.
[17] 杜东晓, 赵龙妹, 贾少轩, 等. 产淀粉酶菌株的筛选鉴定及酶学特性研究[J]. 饲料研究, 2021, 44(19):80-84.DU D X, ZHAO L M, JIA S X, et al. Screening and identification of the amylase producing strain and research on its enzymatic characterization[J]. Feed Research, 2021, 44(19):80-84.
[18] 韩鲁鲁. 碱蓬草根际嗜盐碱细菌的分离鉴定及产淀粉酶菌株的研究[D]. 锦州医科大学, 2020.HAN L L. Isolation and identification of halophilic alkaline bacteria from Suaeda salsa rhizosphere and Study on amylase producing strains[D]. Jinzhou Medical University, 2020.
[19] PUTTANANJAIAH M H, DHALE M A. Glucose released by hydrolytic activity of amylase influences the pigment synthesis in Penicillium sp NIOM-02[J]. Journal of Basic Microbiology, 2013, 53(1):93-97.
[20] KACHAN A V, EVTUSHENKOV A N. Acidification of the culture medium by products of glucose metabolism inhibits the synthesis of heterologous extracellular α-amylase by Bacillus subtilis 168[J]. Applied Biochemistry and Microbiology, 2021, 57(4):443-451.
[21] LIU M M, YANG K, QI Y M, et al. Fermentation temperature and the phenolic and aroma profile of persimmon wine[J]. Journal of the Institute of Brewing, 2018, 124(3):269-275.
[22] COLEMAN M C, FISH R, BLOCK D E. Temperature-dependent kinetic model for nitrogen-limited wine fermentations[J]. Applied and Environmental Microbiology, 2007, 73(18):5875-5884.
[23] FUESS L T, ROGERI R C, ENG F, et al. Thermophilic fermentation of sugarcane vinasse: Process flexibility explained through characterizing microbial community and predicting metabolic functions[J]. International Journal of Hydrogen Energy, 2024, 77:1339-1351.
[24] 朱文优, 周守叙, 凌生隆. 青稞酒液态酿造工艺的研究[J]. 食品工业, 2012, 33(10):49-51.ZHU W Y, ZHOU S X, LING S L. Study on the liquid brewing techniques of barley wine[J]. The Food Industry, 2012, 33(10):49-51.
[25] GAUVRY E, MATHOT A G, COUVERT O, et al. Effects of temperature, pH and water activity on the growth and the sporulation abilities of Bacillus subtilis BSB1[J]. International Journal of Food Microbiology, 2021, 337:108915.
[26] LI S S, YU X L, BEATTIE G A. Glycine betaine catabolism contributes to Pseudomonas syringae tolerance to hyperosmotic stress by relieving betaine-mediated suppression of compatible solute synthesis[J]. Journal of Bacteriology, 2013, 195(10):2415-2423.
[27] 谭沙, 雷孝, 翁盼, 等. 刺葡萄园土壤酿酒酵母的筛选及耐受性分析[J]. 中国酿造, 2020, 39(8):134-137.TAN S, LEI X, WENG P, et al. Screening and tolerance of Saccharomyces cerevisiae from Vitis davidii orchard[J]. China Brewing, 2020, 39(8):134-137.
[28] 徐顶, 孙云权, 刘勇, 等. 白酒蒸馏过程中甑桶内部温度场特征分析[J]. 中国酿造, 2023, 42(1):72-77.XU D, SUN Y Q, LIU Y, et al. Characteristics of the temperature field inside the steaming bucket during Baijiu distillation[J]. China Brewing, 2023, 42(1):72-77.
[29] 刘茗铭, 周阳子, 袁乐梅, 等. 酒曲中高产糖化酶霉菌的筛选及其固态发酵产酶条件优化[J]. 食品与发酵工业, 2018, 44(10):118-123.LIU M M, ZHOU Y Z, YUAN L M, et al. The selection of high yield glucoamylase starter and the optimization of its solid fermentation production enzyme[J]. Food and Fermentation Industries, 2018, 44(10):118-123.
[30] AN Q, HAN M L, BIAN L S, et al. Enhanced laccase activity of white rot fungi induced by different metal ions under submerged fermentation[J]. BioResources, 2020, 15(4):8369-8383.